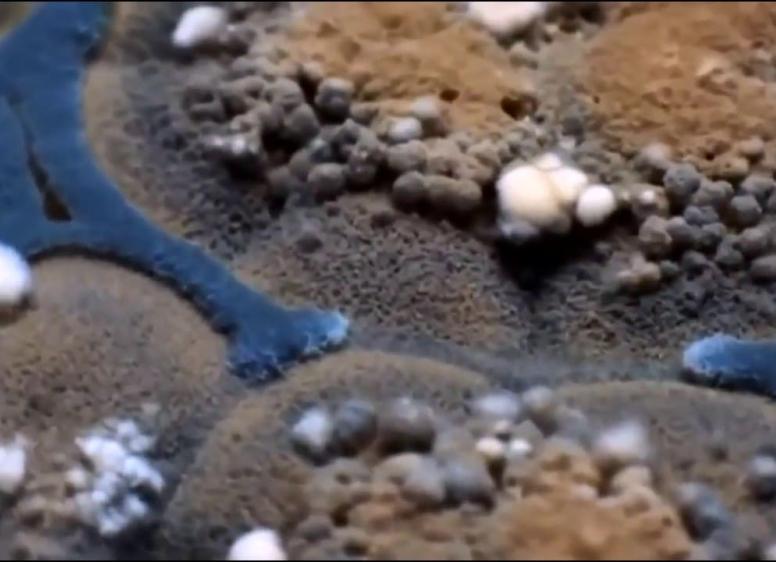

Главные темы
Смотреть все
Все оттенки смеха: Эдгар Райт, трилогия «Корнетто» и трагикомедия взросления
В российском прокате идет культовая хоррор-комедия «Зомби по имени Шон» – первая часть неофициальной трилогии, связанной с цветами мороженого Cornetto. В специальном материале KNMN рассказывает, как эти очень разные фильмы с юмором затрагивали серьёзные (если не сказать - тяжёлые) темы, прославили режиссера Эдгара Райта, а Саймона Пегга и Ника Фроста сделали звездами комедийного жанра

Тореадор, быки и кровь в «Днях одиночества»

Как приручить ксеноморфа в сериале «Чужой: Земля»

Самые запоминающиеся образы из фильмов Пола Томаса Андерсона